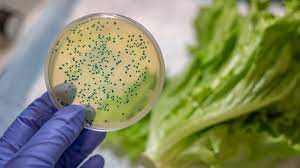

Grande parte das empresas brasileiras de alimentos e bebidas não está atenta à responsabilidade com relação à contaminação de seus produtos e não possui seguros específicos para este risco e nem mesmo apólices de responsabilidade civil geral. A afirmação é da THB Brasil, corretora com atuação global especializada em Seguros, Gerência de Riscos, Resseguros, Consultoria de Benefícios e Affinity.
O cenário é preocupante, já que o risco de contaminação está entre os principais riscos que empresas do setor correm e podem acontecer por diversas razões, muitas delas, inclusive, não estão sob controle da empresa. A melhor forma de a indústria de alimentos e bebidas proteger sua operação e automação é transferir o risco para o mercado segurador.
O cenário é preocupante, já que o risco de contaminação está entre os principais riscos que empresas do setor correm e podem acontecer por diversas razões, muitas delas, inclusive, não estão sob controle da empresa. A melhor forma de a indústria de alimentos e bebidas proteger sua operação e automação é transferir o risco para o mercado segurador.
“Compreender onde estão suas exposições de risco permite um planejamento adequado dos seguros e dos protocolos de segurança. No entanto, a experiência nos mostra que algumas empresas preferem assumir o risco e tratar o tema após o sinistro, diz Camila Feriani, Head de Varejo, Alimentos e Bebidas da THB Brasil.
Para a executiva, em uma suposta contaminação do alimento fabricado, a empresa pode ganhar eficiência e se preservar, se contar com uma consultoria de riscos dedicada, além da contratação do seguro de Responsabilidade Civil para Produtos Contaminados. O mercado segurador passou por grandes avanços neste sentido e o seguro aliado a um plano de contingência podem minimizar os impactos causados em casos como este.


